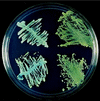

Detection of Candida dubliniensis in oropharyngeal samples from human immunodeficiency virus-infected patients in North America by primary CHROMagar candida screening and susceptibility testing of isolates
- PMID: 9738058
- PMCID: PMC105102
- DOI: 10.1128/JCM.36.10.3007-3012.1998
Detection of Candida dubliniensis in oropharyngeal samples from human immunodeficiency virus-infected patients in North America by primary CHROMagar candida screening and susceptibility testing of isolates
Abstract
Candida dubliniensis has been associated with oropharyngeal candidiasis in patients infected with human immunodeficiency virus (HIV). C. dubliniensis isolates may have been improperly characterized as atypical Candida albicans due to the phenotypic similarity between the two species. Prospective screening of oral rinses from 63 HIV-infected patients detected atypical dark green isolates on CHROMagar Candida compared to typical C. albicans isolates, which are light green. Forty-eight atypical isolates and three control strains were characterized by germ tube formation, differential growth at 37, 42, and 45 degreesC, identification by API 20C, fluorescence, chlamydoconidium production, and fingerprinting by Ca3 probe DNA hybridization patterns. All isolates were germ tube positive. Very poor or no growth occurred at 42 degreesC with 22 of 51 isolates. All 22 poorly growing isolates at 42 degreesC and one isolate with growth at 42 degreesC showed weak hybridization of the Ca3 probe with genomic DNA, consistent with C. dubliniensis identification. No C. dubliniensis isolate but only 18 of 28 C. albicans isolates grew at 45 degreesC. Other phenotypic or morphologic tests were less reliable in differentiating C. dubliniensis from C. albicans. Antifungal susceptibility testing showed fluconazole MICs ranging from </=0.125 to 64 microgram/ml. Two isolates were resistant to fluconazole (MIC, 64 microgram/ml) and one strain was dose dependent susceptible (MIC, 16 microgram/ml). MICs of other azoles, including voriconazole, itraconazole, and SCH 56592, for these isolates were lower. C. dubliniensis was identified in 11 of 63 (17%) serially evaluated patients. Variability in phenotypic characteristics dictates the use of molecular and biochemical techniques to identify C. dubliniensis. This study identifies C. dubliniensis in HIV-infected patients from San Antonio, Tex., and shows that C. dubliniensis is frequently detected in those patients by using a primary CHROMagar screen.
Figures

References
-
- Coleman D C, Sullivan D J, Bennett D E, Moran G P, Barry H J, Shanley D B. Candidiasis: the emergence of a novel species, Candida dubliniensis. AIDS. 1997;11:557–567. - PubMed
-
- Moran G P, Sullivan D J, Henman M C, McCreary C E, Harrington B J, Shanley D B, Coleman D C. Antifungal drug susceptibilities of oral Candida dubliniensis isolates from human immunodeficiency virus (HIV)-infected and non-HIV-infected subjects and generation of stable fluconazole-resistant derivatives in vitro. Antimicrob Agents Chemother. 1997;41:617–623. - PMC - PubMed
-
- National Committee for Clinical Laboratory Standards. Reference method for broth dilution antifungal susceptibility testing of yeasts: approved standard. Document M27-A. Wayne, Pa: National Committee for Clinical Laboratory Standards; 1997.
Publication types
MeSH terms
Substances
Grants and funding
LinkOut - more resources
Full Text Sources
Medical
Miscellaneous

